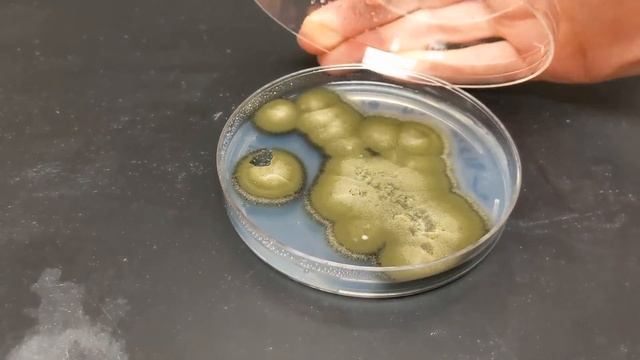
2019 IPWA Grant Recipient Alexiev Boreal Toad Fungal Pathogen Research смотреть онлайн

Г
Грибные мифы
Смотреть все онлайн видео автора канала
 01:22
01:22
Салат из Баклажанов..Baqlajonli salat
 12:04
12:04
Microbiología de los Alimentos (Parte 3)
 01:30
01:30
День Роснефти
 00:30
00:30
Бурение колодца Воскресенский район п. Ручейный
 10:02
10:02
Майнкрафт с гигантскими грибами шок!
 03:00
03:00
VEGAN BBQ PULLED 'PORK' SANDWICH | Quick & Easy | Clean & Healthy | Tyler Health
 01:32
01:32
Копы фнаф!!!!
 02:32
02:32
Homemade Gummy candy / պատրաստում եմ Գամմի կոնֆետներ
 00:16
00:16
Грибы в Одессе
 03:59
03:59
Vrganji - 10 Extra
 42:52
42:52
Опять нашь милый mc.randomcraft.ru
 01:41
01:41
In Penicillium / Aspergillus the conidial chains are borne at the tips of
 04:10
04:10
В Приднестровье отменяют проверки на малых предприятиях и снижают стоимость патента
 09:36
09:36
балди пж не пишите что бы я продолжил а то опять трусы менять😭
 00:04
00:04
продукты, которые нельзя есть при гастрите
![Крутое жизненное Напоминание! [НОВИНКА 2019] смотреть онлайн](https://pic.rutubelist.ru/video/2025-02-03/39/f9/39f9752bff59bbe6e8916fe5fde8a344.jpg) 04:52
04:52
Крутое жизненное Напоминание! [НОВИНКА 2019]
 00:09
00:09
Новинки свадебных платьев
 06:06
06:06
УГАДАЙ ПЕСНИ ПО СТРОЧКАМ ЗА 10 СЕКУНД
 00:15
00:15
Картошечка с грибами, сыром,фаршем в духовке
 03:45
03:45
SNOFLA FT N2.wmv
 03:19
03:19
Закуска грибочки с беконом.
 10:56
10:56
Implementasi Pengendalian Hayati pada Tanaman Kelapa - Pengendalian Hayati
 32:09
32:09
Игры на траве
06:37
06:37
2019 IPWA Grant Recipient Alexiev Boreal Toad Fungal Pathogen Research
Страница 1
Вперед →
Рады Вас приветствовать на ruvideo.click, только у нас в кинотеатре у вас есть возможность сделать выбор из огромного количества и посмотреть интересующие онлайн фильмы. Без регистрации, онлайн и при чем совершенно бесплатно вы здесь можете смотреть любой фильм или видео, без отправки смс сообщений и пустой траты денег, все что необходимо это включить и получать удовольствие от просмотра. Лучшего качества видео вы просто не найдете. У нас база видео контента обновляется ежедневно, и это касается не только фильмов, но и сериалов и телепередач. Мировые премьеры как отечественного так и зарубежного кинематографа появляются на сайте одновременно с выходом в прокат. Доброго времени суток и приятного всем просмотра!
Лучше чем онлайн кинотеатр ULTRADOX!